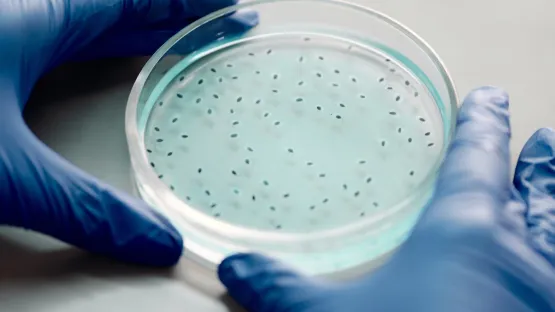
Culture des cellules - Air Liquide

Domaines d’application
PHARGALIS™3, l’oxygène (O2) d’Air Liquide dédiée à l'industrie pharmaceutique pour être mis en contact avec les médicaments
L’oxygène est un facteur limitant du processus microbien car il est consommé dans les milieux de cultures cellulaires aérobies.
L’enrichissement des bioréacteurs en oxygène pharmaceutique PHARGALIS™3 contribue à intensifier les performances des bioprocédés en terme de productivité et de rendement.
L’offre de culture cellulaire d’Air Liquide dédiée aux procédés de bioproduction, de l’incubateur au bioréacteur - fermenteur minimise les risques de non conformité et maximise l’efficacité des cultures.
Spécifications
Qualité et respect des exigences réglementaires
Les spécifications chimiques de l’oxygène PHARGALIS™3 sont conformes aux exigences décrites dans les trois principales pharmacopées européenne, américaine et japonaise: Oxygène N°0417 (Ph.Eu), N° 7782-44-7 (USP-NF).
| Oxygène O2 | Technique d'analyse | Specifications | |
|---|---|---|---|
| Identité | Analyseur paramagnétique | Oxygène | |
| Pureté(O2) | Analyseur paramagnétique | ≥ 99.5 | % |
| Humidité (H2O) | Hygromètre électrolytique | ≤ 67 | ppm v/v |
| Monoxyde de carbone (CO) | Analyseur Infrarouge | ≤ 5 | ppm v/v |
| Dioxyde de carbone (CO2) | Analyseur Infrarouge | ≤ 300 | ppm v/v |

Fiches de données de sécurité
Retrouvez le document de référence PHARGALIS™ 3 (oxygène) dont vous avez besoin pour vos industries pharmaceutiques.
Modes d’approvisionnement
Avez-vous des questions sur PHARGALIS™ 3 ? Veuillez remplir notre formulaire de contact.
Nos experts vous répondront dans les 24 heures.
Vous serez peut-être intéressé par…
En savoir plus
Protégez vos produits et vos installations grâce à l’inertage
Contrôle de température d’une réaction chimique - ALASKATM
Optimisez votre procédé de lyophilisation grâce au froid cryogénique
Broyage à température contrôlée et cryobroyage à l’azote liquide
Culture cellulaire sous atmosphère contrôlée en incubateur, bioréacteur, fermenteur
Garantissez la conformité aux BPF de vos équipements et installations de gaz pharmaceutiques
Armoire d’identification des gaz à réception
Atomisation par cryo-cristallisation d’ingrédients riches en matière grasse
Nouveaux enjeux pour les gaz dans la fabrication des médicaments
L’inertage azote: pourquoi et comment l’azote est-il utilisé dans les applications d’inertage?
Bien utiliser les gaz en R&D et production biopharmaceutique
Risque d'incendie et d’explosion de gaz
Comment sont utilisés les gaz dans le conditionnement de médicaments?
Azote pharmaceutique : caractéristiques et usages
PhargalisTM , la gamme de gaz et services dédiée à l’industrie pharmaceutique et à la bioproduction
Questions fréquentes
Qu'est ce que la pharmacopée ?
Quels sont les différents éléments du conditionnement des médicaments ?
A quoi servent les gaz pharmaceutiques ?
Quels sont les principes de la lyophilisation pharmaceutique ?
Comment mettre en place un contrôle des gaz pharmaceutiques ?
Comment fonctionne l'inertage ?
Qu'entend-on par gaz inertes ?
Quels sont les avantages d'avoir un analyseur Oxygène sur une installation d'inertage?





